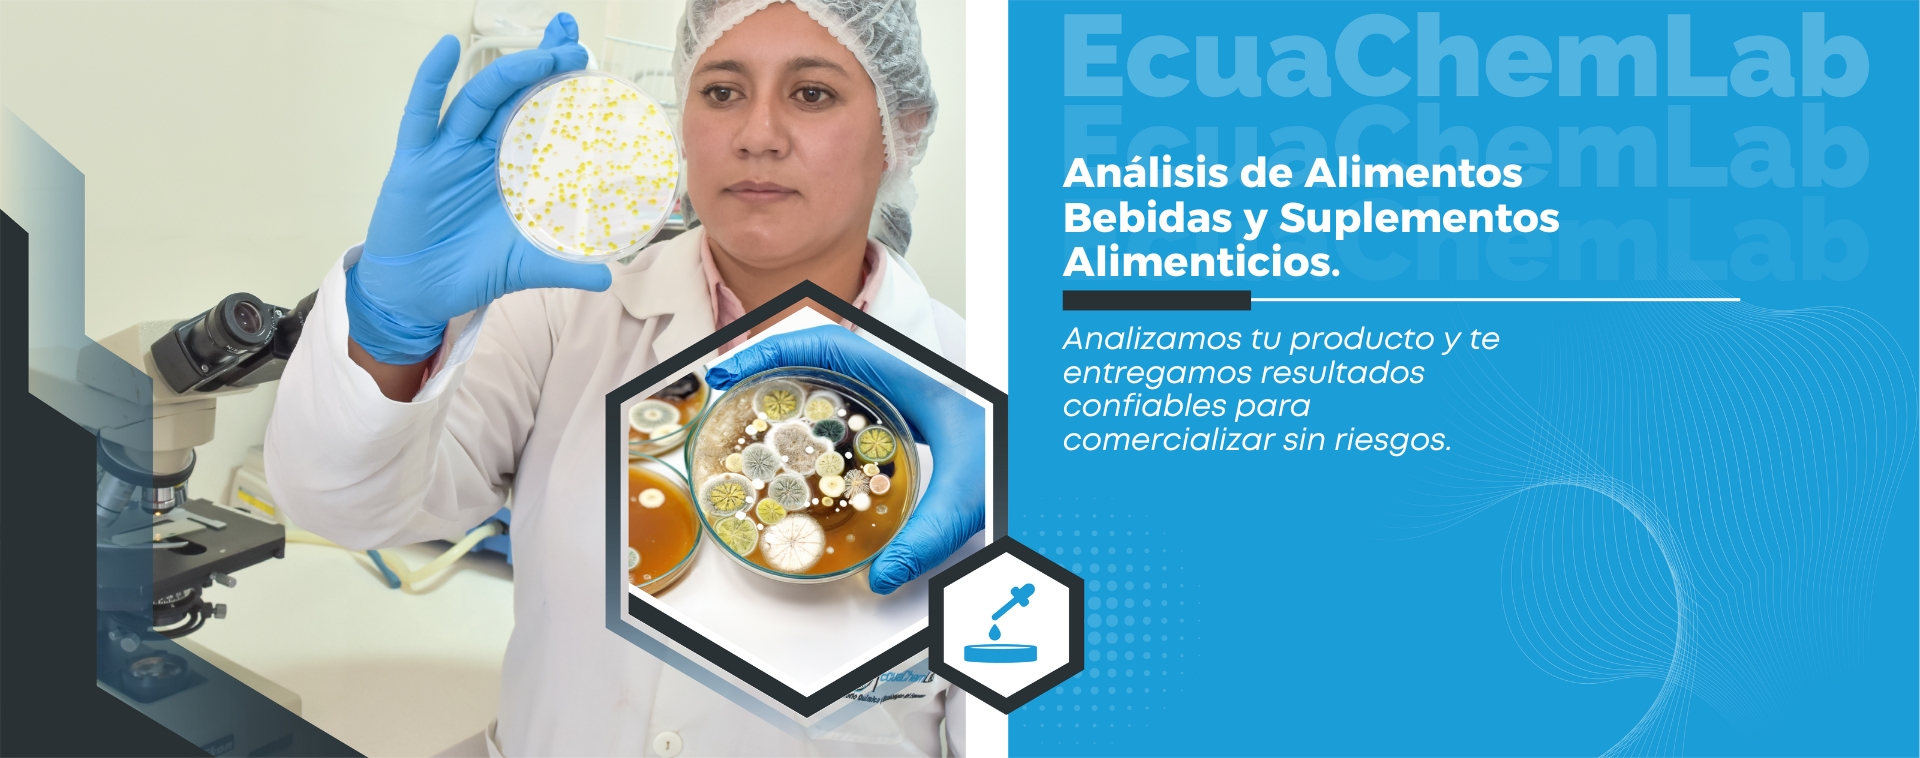
Análisis de Alimentos, Bebidas y Suplementos Alimenticios

Saber Más
Saber Más
 Saber Más
Saber Más
 Saber Más
Saber Más
 Saber Más
Saber Más
 Saber Más
Saber Más
 Saber Más
Saber Más
Conoce Lo Nuevo para Ti
Laboratorio Ecuachemlab está registrado en la Agencia Nacional de Regulación, Control y Vigilancia Sanitaria - ARCSA, como OEC (Organismo Evaluador de la Conformidad) para realizar análisis de control de calidad post registro o post notificación de los productos de uso y consumo humano sujetos a control y vigilancia sanitaria.
Sobre Nosotros
EcuaChemLab, excelencia analítica Acreditada.
Desde hace 10 años, trabajamos junto a ti brindando servicios de análisis fisicoquímicos, microbiológicos en productos generados por la industria Alimenticia, Farmacéutica, Cosmética, Veterinaria y Agroindustrial, con precisión y compromiso. Estamos acreditados por el Servico de Acreditación Ecuatoriana SAE bajo el NÚMERO SAE LEN 17-001, conforme a la Norma NTE INEN ISO/IEC 17025:2018, equivalente a la ISO/IEC 17025:2017, lo que garantiza la competencia técnica de nuestros resultados. Confía en un laboratorio que asegura calidad, cumplimiento y respaldo.
Proceso de Las Muestras
Llevamos 10 años de experiencia, brindando análisis confiable para diversas industrias. Conoce cómo es nuestro proceso técnico y transparente.
¿Por qué Ecuachemlab?
Aseguramos precisión, cumplimiento normativo y respaldo técnico en cada análisis.
Somos mucho más que un laboratorio
Servicios Analíticos
Ofrecemos servicios analíticos diseñados para cumplir con normas técnicas, ahorrar tiempo y asegurar tu éxito en el mercado.
Somos los expertos de confianza Mantenemos las cosas simples
Cada análisis es más que un resultado: es la tranquilidad de saber que estás cumpliendo con normas, cuidando tu producto y protegiendo tu reputación. Precisión, respaldo y compromiso en cada informe.
Síguenos en Todas Nuestras Redes Sociales
En nuestro laboratorio, no solo trabajamos por la calidad en cada análisis, también queremos acercarte el conocimiento y la innovación en todo momento. Síguenos en todas nuestras redes sociales y descubre noticias, consejos, actualizaciones sobre normativas y datos importantes





